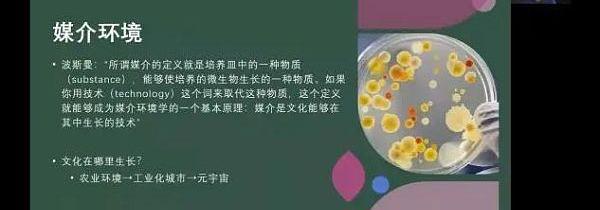

目前元宇宙依旧处于探索中,面临着许多挑战和机遇,需要相关各类关键技术的支撑。4月17日上午,以“元宇宙技术、机遇与探索”为主题的在线沙龙顺利召开。
北京大学国际关系学院翟崑教授作了关于《元宇宙与中国国家战略创新的关系》的分享。翟崑教授认为数字时代的发展需要我们在制定国家战略时做出创新和调整,吐故纳新,并指出了目前元宇宙存在的问题:目前缺乏从国家战略竞争这一角度对元宇宙进行分析的观点。
他认为人的头脑进入元宇宙时,人的身体也应当进入,形成整体,而不能分裂开来。由于头脑意识和人的身体分裂,缺乏对元宇宙沉浸式的了解,所做出的国家或国际战略会存在战略认知赤字和战略运筹赤字的问题。
国际的角度,翟崑教授提出了“我世界”的概念——数字时代发展到当今阶段我们所处的世界,“我”是指元宇宙世界的中心,是一种认同,是元宇宙的主要行为者,而元宇宙与国际世界是相互建构的。
此外,翟崑教授从六个角度分析了元宇宙给当前世界带来的变化。翟崑教授还将元宇宙和人类命运共同体进行了比较分析,认为元宇宙也是在塑造一个人类命运共同体世界,可以实现共商共建共享的原则,网络空间命运共同体使得国际之间有了新的沟通方式,作为人类命运共同体的首倡者,中国可以将元宇宙应用于“一带一路”和人类命运共同体当中,实现全人类的共同发展。
知情人士:Meta向元宇宙技术人员支付的薪酬高达100万美元:4月7日消息,据知情人士报道,Facebook母公司Meta向程序员“支付的费用远远高于许多游戏公司”,能够构建虚拟现实游戏、应用程序和技术的程序员可以获得 60 万美元到接近 100 万美元的总薪酬。[2023/4/7 13:50:41]
武汉大学媒体发展研究中心肖珺教授分享了《面向元宇宙:虚实融合传播中的文化认知》。肖珺教授主要从四个方面阐述了元宇宙所造成的虚实融合传播生态。他指出,元宇宙正在重塑社会的传播生态,虚实融合的数字交往,会改变我们的媒介化生存方式和社会生活,进而有可能生成人类历史上一种新的文明。
其次,他指出,元宇宙的传播特征有四个方面——第一,元宇宙是一种高度复杂的系统性的工程,需要技术支撑;第二,元宇宙提供的是一种深度沉浸的用户体验,在未来会实现现实世界与虚拟世界的无障碍的连接;第三,元宇宙是一种数字交往当中的开放共创系统,全人类共创一个更加开放的系统,并且进行文化生产;第四,元宇宙会带来虚实交替的两栖生活,从而推动人的社会文化的整体的迁移。
除此之外,肖珺教授还指出人类已经在自己的文明化实践过程中进行了元宇宙的尝试和应用,因此人类的社会文化实践的本身在伴随元宇宙技术的弥散过程当中会出现很多新的现象,需要不断去跟进和研究,同时也需要人类通过协商和共创去建立元宇宙的开放环境和公平规则,使得元宇宙可以给社会文化生活带来更积极向善的力量。
韩国能源巨头 Daesung 成立 8450 万美元规模元宇宙基金:金色财经报道,韩国城市燃气和能源巨头 Daesung 的风险投资子公司 Daesung Private Equity 近日成立了规模 1100 亿韩元(约合 8450 万美元)的元宇宙基金 Daesung Metaverse Scale-up Fund,该基金将重点投资于 AI、XR、区块链和数字孪生技术等领域。
韩国政府支持的母基金 Korea Venture Investment Corp. 为该元宇宙基金注资 600 亿韩元(4600 万美元),其他有限合伙人包括韩国工业银行 (IBK)、Shinhan Capital Co. Ltd. 和Daesung Group 子公司。
据悉,Daesung Private Equity 之前投资过 PUBG、Battlegrounds 游戏制造商 KRAFTON 和韩国加密货币交易所 Upbit 运营商 Dunamu Inc。(forkast)[2022/12/2 21:17:54]

韩国新韩银行推出Shinamon元宇宙平台:金色财经报道,据韩国媒体周三报道,韩国新韩银行(Shinhan Bank)开设了一个“元宇宙”网站,提供所谓的金融和非金融服务,声称是韩国首家提供这种平台的银行。据报道,所谓的“Shinamon”元宇宙平台将包括金融、医疗、艺术和体育等领域。
该银行表示,今年6月对Shinamon的服务进行了为期5天的测试,吸引了8.5万名游客。在此之前,新韩银行在区块链和加密货币相关服务方面进行了多次试验。(forkast)[2022/12/1 21:15:09]

清华大学医学院高小荣教授团队博士生史南林为大家介绍了《从元宇宙到脑机接口》,并从三个角度谈论了元宇宙和脑机接口的相互作用。
首先,史南林阐述了元宇宙可以为脑机接口研究提供的新方向和新思路,认为元宇宙的存在使得脑机接口实验可以从外部的物理世界搬移到数字世界当中,实验的刺激信号从电脑屏幕搬到VR眼镜上,给使用脑机接口的人更沉浸的体验,也凸显出VR眼镜的便携性。同时,元宇宙的万物互联特点使得元宇宙为多人同步脑机接口提供了新平台。
NFT收藏家punk6529推出元宇宙项目OM:4月15日消息,拥有超32万粉丝的NFT流行收藏家punk6529宣布其推出了元宇宙项目OM。该项目长期计划是启动10个自治城市,每个城市的最大人口为1000万。第一个城市(创世纪城)的博物馆区今天已发布alpha版本,可以展出Cryptopunk、Fidenza、BAYC和Artblocks 等NFT。OM预计将在6月或7月过渡到公测版。(Cointelegraph)[2022/4/15 14:26:17]
除此之外,元宇宙也给脑机接口带来了新的应用出口,除了脑机接口现在已有的应用于残障人士残障功能的替代和修复,还可以应用于游戏当中,例如在VR眼镜中通过脑机接口控制人的运动从而获取游戏体验。
其次,脑机接口可以为元宇宙提供新的认识。例如脑纹识别可以作为元宇宙中的独一无二的身份认证,脑机接口可以给元宇宙中的人的肢体提供较高的控制感,通过脑机接口可以使得虚拟世界中的人的注意力、疲惫状态等得到及时反映,从而映射到物理世界中。最后,现有科技水平的发展之下元宇宙和脑机接口的融合方式以及发展也值得关注。
元宇宙的愿景之一是即插即用,脑电设备依旧有这样的愿景,同时两者都追求设备的舒适性和便携性,以及信息传递的低延迟,脑机接口和元宇宙的协同发展会是两者进步的有效方式。

富国银行:元宇宙未来5年将为英伟达提供100亿美元市场增值份额机会:金色财经报道,英伟达公布三季度财报后,富国银行分析师Aaron Rakers发表评论称,未来5年,元宇宙将为英伟达提供100亿美元的市场增值份额机会,而这个能够带来百亿美元增长的引擎是Omniverse。Omniverse平台的发布,奠定了元宇宙工业的技术的基础,自11月初平台发布以来,英伟达股价已上涨29%,过去三个月内上涨了66.6%。[2021/11/23 7:05:46]

清华大学精密仪器系曹良才教授团队博士后何泽皓分享了《全息通讯在元宇宙中的技术探索》,从五个方面对基于计算全息技术的元宇宙应用进行了分析。
他认为元宇宙是一个去中心化的在线的真实的虚拟环境,其中的场景需要3D的形式去进行表达和展示。而三维显示的效果是元宇宙虚拟环境发展的一大问题,全息显示作为一种面向三维、面向未来的三维显示方案,适用于元宇宙的三维信息的展示中。计算全息和虚拟现实交叉应用与元宇宙领域,元宇宙的真实感和沉浸感能够得到增强。
何泽皓介绍到,三维成像技术和设备、三维信息计算和优化算法,再加之全息显示、全息通讯系统,可以实现元宇宙中三维场景的实时获取和重建。


清华大学科学史系胡翌霖副教授分享了《从技术进化论看元宇宙》。胡翌霖副教授认为元宇宙不是未来的新的单一事物,它是一个人类技术史当中的趋势,是人类一直在追求的通过技术建立一种想象的世界,是一个技术系统、技术环境。他通过达尔文的进化对生物进化和技术进化进行了类比,元宇宙技术受到自然环境的物理规律的制约,同时元宇宙技术也在不断构成新的自然文化技术环境。
从洞穴壁画到工业时代再到信息时代,生产力和意识的革命都会造就新的环境和圈层。元宇宙作为其中最新的圈层,是具有独立性的,区别于我们现在所在的社会圈层,具有可生活的可能性,交际圈的拓展以及利益的获取,所以人们才会进入到元宇宙中。
同时,胡翌霖副教授也提出了对于元宇宙尽可能还原或重新创造一个逼真的虚拟世界的质疑,认为高度模仿现实世界去打造虚拟世界在某些方面会造成算力和资源的浪费。

清华大学新闻与传播学院沈阳教授团队博士生向安玲以《“三性”与“三能”:元宇宙研究进展分享》为主题汇报了团队近期在元宇宙领域的研究进展。
她提到,围绕元宇宙“三性”与“三能”,团队展开了包括时空美学等与其他产业的结合应用、隐私问题、虚拟数字人、数字藏品报告等众多研究,并将发布实时更新的元宇宙产品指数评估榜单。她提到,该榜单从市场的适用性、技术的成熟度、整个产品体系的完备性和媒体期望、媒体热度五个维度进行量化数据的测评。
此外,她还分享了团队构建的时空智能综合应用平台:无尽之塔。在无尽之塔中,人们可以随意选择并切入到一个细分的空间当中,比如:虚拟会议、虚拟展览,或者是一些其他社交场景的体验。
以提供了30多种标准化的会议场景供用户选择的虚拟会议系统为例,在虚拟会议中,用户可进行肢体性、语言性的交互,甚至是材料共享。
向安玲分享,自然人、虚拟人和机器人的融合是团队的研究主题之一。团队认为,将三者的数据运作引擎打通之后即可实现“三生合一”,从而实现现实空间和虚拟空间真正的实时性的联动。
基于人机融生性,团队虚拟人平台设计上线了一键生成虚拟数字人的功能。当然,虚拟数字人可以在团队构建的时空智能综合应用平台“无尽之塔”中进行一系列活动。



清华大学新闻与传播学院沈阳教授对此次沙龙进行了总结。通过分析元宇宙和传统移动互联网的差异,沈阳教授指出当下存在的元宇宙应用并不高频的问题。沈阳教授还结合近期有关元宇宙的事件分析了元宇宙的发展趋势。
他认为,目前元宇宙相关业界的发展是有明显进展的,包括美国斯坦福大学设立元宇宙和虚拟人课程、东京大学等一些学校和机构都对元宇宙进行了深度研究。最后,他表示元宇宙的发展需要各界的共同探讨和分享,打造开放和谐的元宇宙构建环境。
前些天在国外某网络社交平台上,一位网友控诉自己在某元宇宙虚拟空间中进行“VR睡眠”的时候惨遭“VR”.
1900/1/1 0:00:00关键要点鉴于整体市场降温,数字地块的二级销售下降了54%,但仍比2021年第三季度增长了865%。一级销售量因新地块的发行而增长23%.
1900/1/1 0:00:00ERC721R像是一种标志,打响了项目方权力约束和NFT铸造者权益保护第一。原文标题:《ERC721R不是万金油,但是会有千千万万个「ERC721R」出来!》ERC721R是什么?4月11日,
1900/1/1 0:00:004月9日消息,随着加密货币在全球的兴起并且越来越多地被采用,纳米比亚央行最近发布其金融科技监管框架,并宣布有意推出其中央银行数字货币。纳米比亚银行表示,“我们不能忽视CBDC,这是一个现实.
1900/1/1 0:00:00“There''svalueintheoriginal。”“原创是有价值的。”最近很多人都在说cc0,而且一直说“cc0的时代即将到来.
1900/1/1 0:00:00今日,中国互联网金融协会、中国银行业协会、中国证券业协会联合发布关于防范NFT相关金融风险的倡议,倡议中表明坚决遏制NFT金融化证券化倾向,从严防范非法金融活动风险,自觉遵守行为规范.
1900/1/1 0:00:00